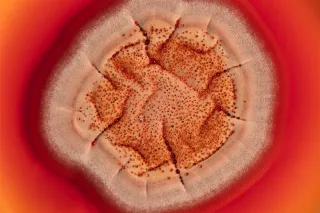
Mikrobi
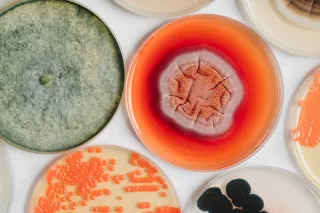
Mikrobit

Production of sustainable next-generation biocolours
Sustainable natural colourants are emerging as alternatives to fossil-based synthetic dyes, yet scalability, performance and sustainability remain key challenges.
Explore microbial production systems as a promising route towards next-generation bio-based colour solutions. VTT will present a synthetic biology approach to anthraquinone dyes, Vienna Textile Lab will share its experience of working with microbes that natively produce colour, and Fashion for Good will discuss how collaborative innovation platforms can help bridge the gap between technology development and real-world adoption.
On this page:
Register to watch
Is this for me?
Work in textiles, fashion or materials innovation and want to explore how biobased and microbial colourants can replace fossil-based synthetic dyes.
Are part of a biotech, startup or R&D organisation exploring industrial applications of synthetic biology beyond pharma and food.
Are a brand, innovation manager or sustainability lead looking for viable alternatives to conventional textile dyes.
Are an ecosystem builder, investor or platform organisation interested in how research, startups and brands collaborate to bring biocolours to market.
Agenda
- Welcome and opening – Michael Healy-Rehn, Business Development Manager, Industrial Biotechnology, VTT
- Sustainable anthraquinone pigment production with a SynBio approach – Jorg de Ruijter, Research Team Leader, Production Host Engineering, VTT
- Vienna Textile Lab: Microbial Pigments as an Alternative to Synthetic Dyes in the Textile Industry – Karin Fleck, Founder and CEO, Vienna Textile Lab
- Fashion for Good: From Lab to Mill: Evaluating and Scaling Biogenic Colourants – Iro Kofokotsiou, Senior Analyst, Fashion for Good
- Q&A
Speakers

Michael Healy‑Rehn is a Business Development Manager in Industrial Biotechnology at VTT (Technical Research Centre of Finland). He works at the interface of research and industry, supporting the commercialisation of biobased materials, proteins, and microbial fermentation technologies through strategic partnerships, EU projects, and spin‑out activities.

Jorg de Ruijter (D.Sc., Tech) has over 10 years of experience in microbial biotechnology research. He currently leads the Production Host Engineering research team at VTT Technical Research Centre of Finland. The team has a strong expertise in metabolic engineering and synthetic biology for a wide range of bacterial, yeast, and filamentous fungal production systems. Recently, main research topics have been biocolours, microbial lipids, and PHAs, combined with development of high-throughput automation workflows to increase the efficiency of the research.

Iro is an Innovation Associate at Fashion for Good, where she works on the scouting and validation of innovative technologies in the textile industry. With a background in chemistry, she focuses on advancing low-impact wet processing, including solutions for dyeing, wastewater treatment, and decarbonisation. Her work involves working closely with innovators and industry partners to assess technologies in manufacturing environments and support their adoption across the supply chain, leading FfG's current project on testing biogenic dyes.

Karin Fleck, the founder and CEO of VTL, brings a wealth of experience to the company. Holding a degree in Technical Chemistry from TU Wien and a PhD in Applied Chemistry from RMIT University in Melbourne, Australia. Over 10 years of international management experience Startup Experience, Board Member Platform Green Chemistry Austria